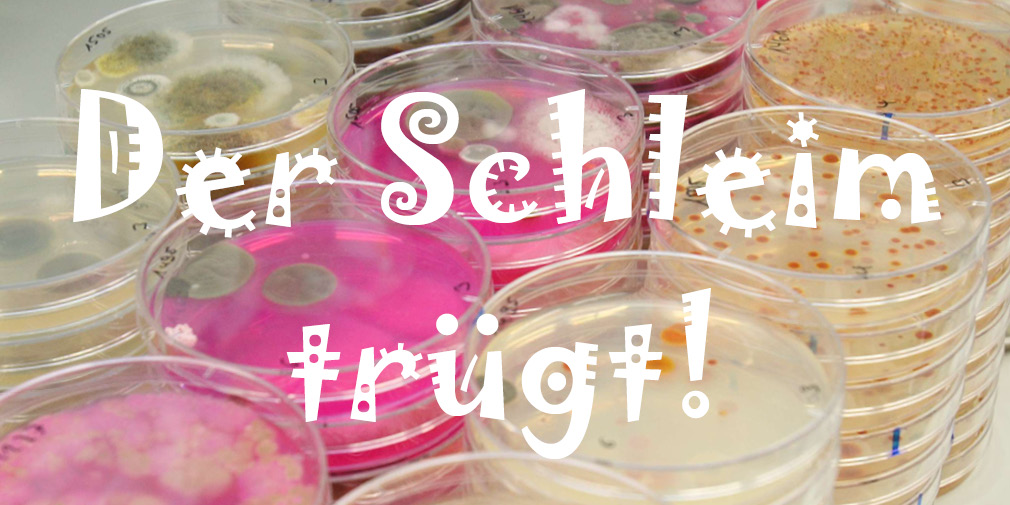

Das LTZ Augustenberg bietet eine vielfältige Ausbildung mit modernen Labortechniken an. Die Schwerpunkte liegen im Bereich Mikrobiologie, Molekularbiologie, Botanik und Diagnostik von Schadorganismen an Pflanzen. Sie arbeiten in verschiedenen Referaten und erhalten ebenfalls Einblick in die chemische Analytik. Es erwartet Sie ein spannender und abwechslungsreicher Ausbildungsplatz, bei dem Sie von Anfang an in den Arbeitsprozess miteinbezogen werden.
Weitere Informationen finden Sie im PDF "Ausbildungsplatz Biologielaborantin/Biologielaborant" oder in unserem "Ausbildungsvideo Biologielaborantin/Biologielaborant" auf YouTube.